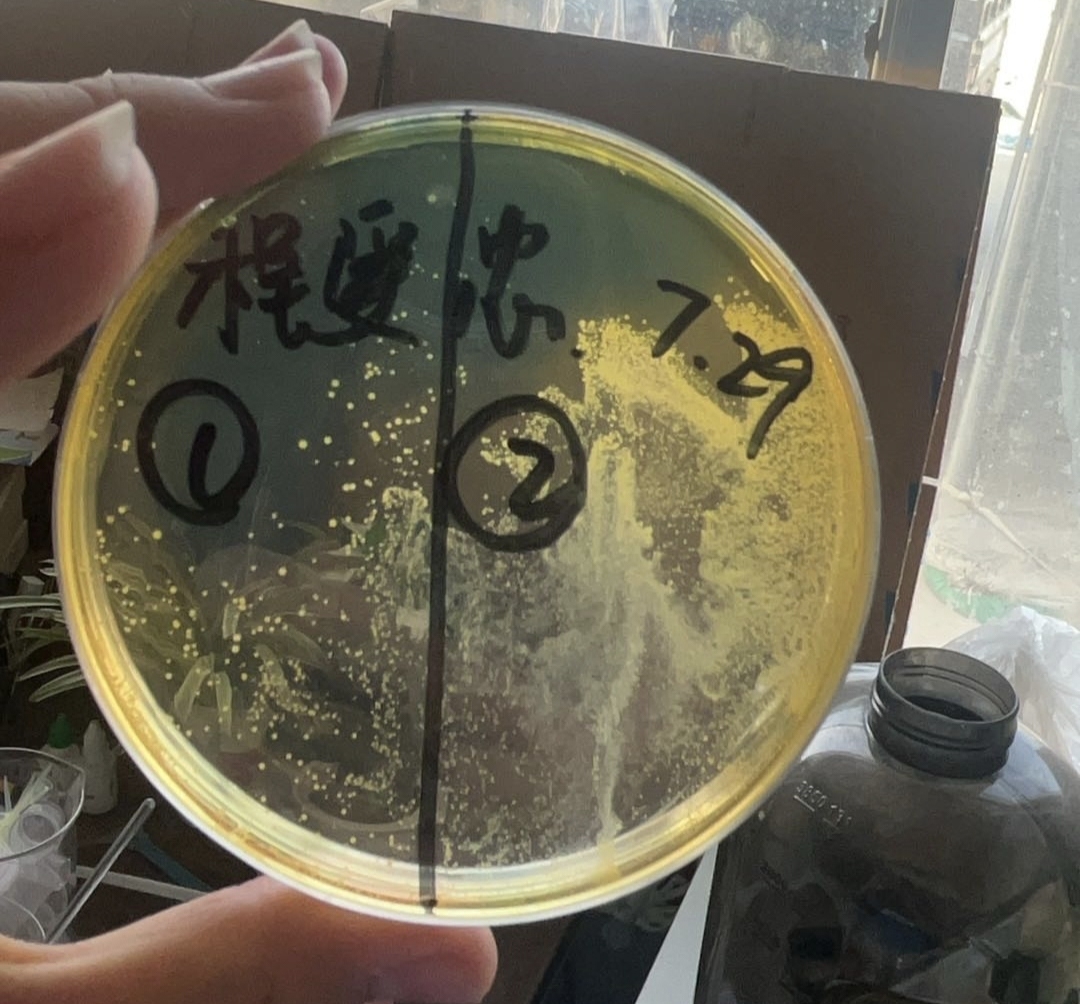
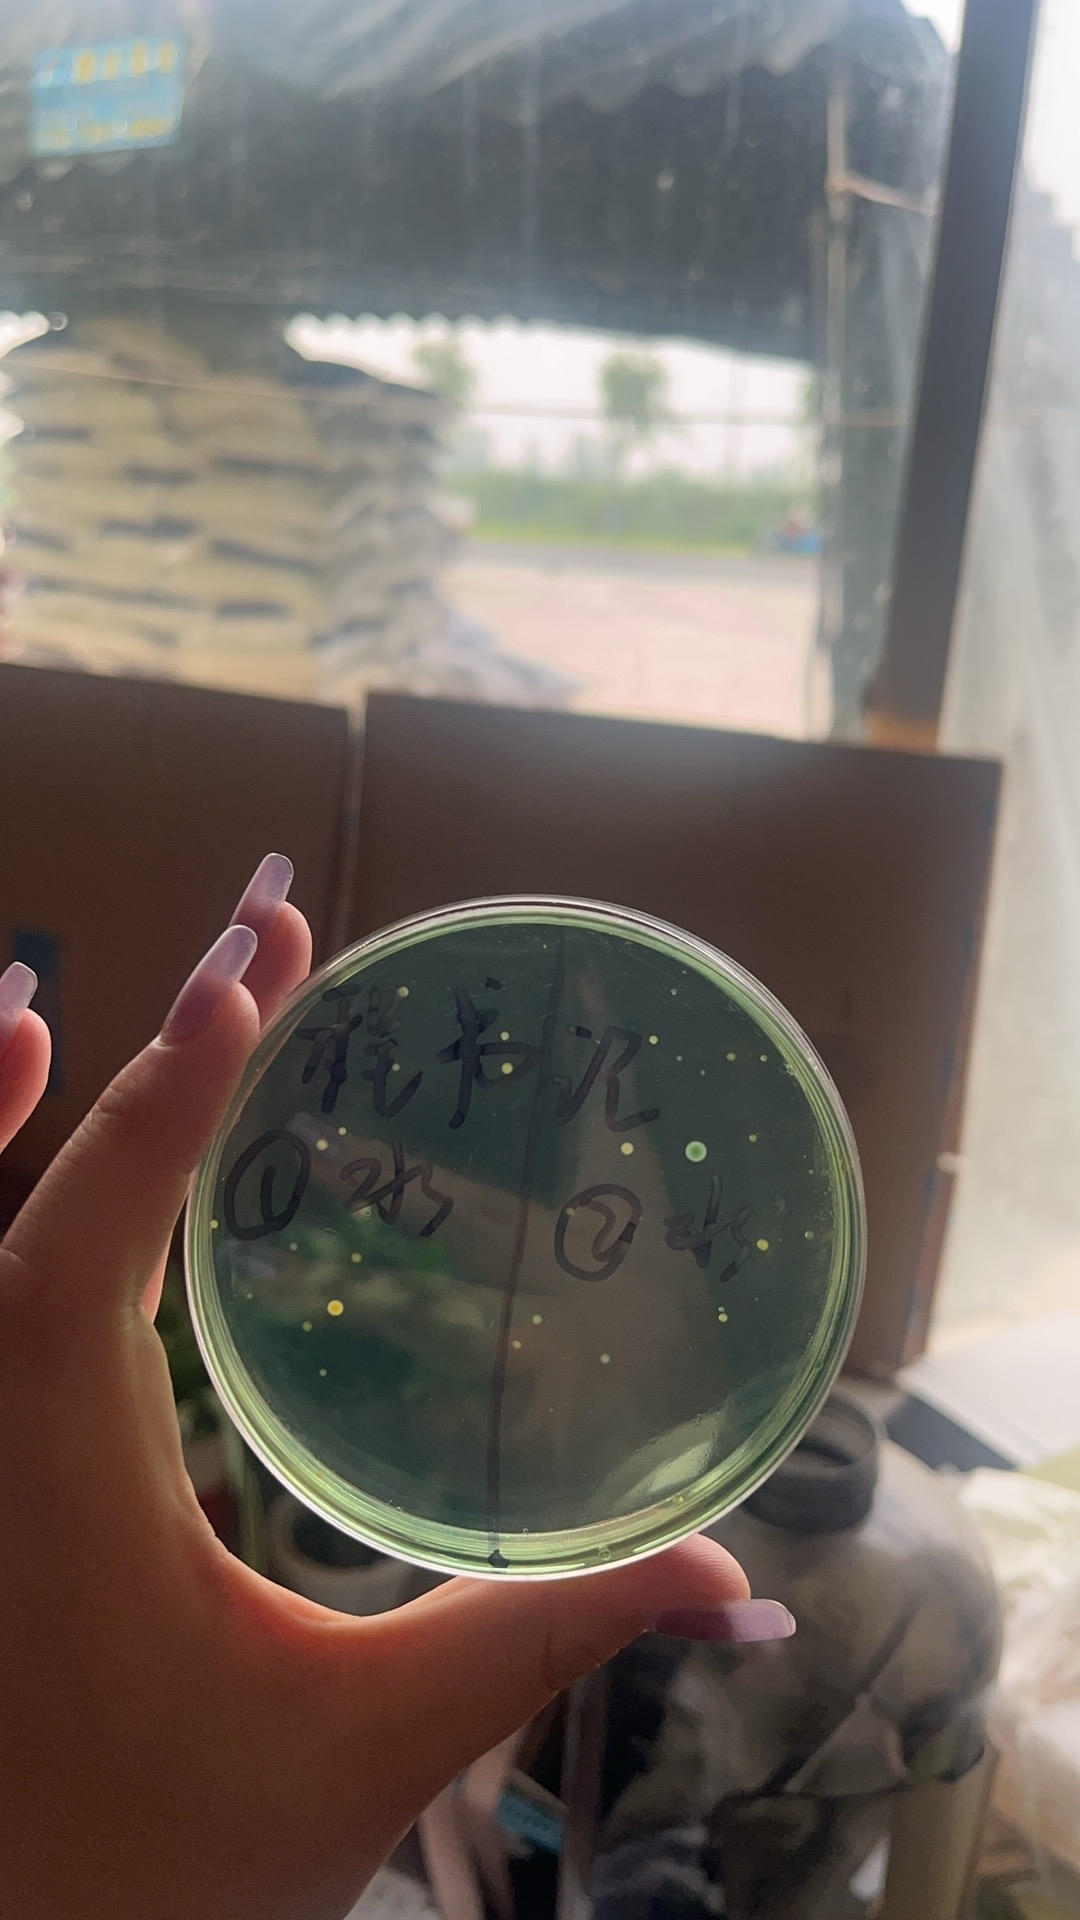

弧菌为革兰氏阴性致病菌,种类很多,在水产养殖过程中,常见并且危害性较大的弧菌有副溶血弧菌、哈维氏弧菌、霍乱弧菌、溶藻弧菌、灿烂弧菌、鳗弧菌等等,它主要有以下几个基本特性:
1.条件致病菌
当弧菌数量达到一定水平、对虾体质弱、水体环境恶化的情况下才会引起对虾疾病。
2.温度
弧菌喜温,一般在10-37摄氏度都能正常生存,且大量繁殖。
3.盐度与PH值
当ph值在6.5-9,盐度比较高的水体中,弧菌的繁殖是最快的,种类也多,而淡水中弧菌种类就相对较少。
4.兼性厌氧
在没有氧气的环境中它也能快速繁殖,危害水体。氧气充足对弧菌还是有一定抑制作用的,因为充足的氧气可以提高对虾的免疫力,从而在一定程度上抵抗弧菌。
地点:滨州市博兴县乔庄镇
时间:2024年7月29日
养殖面积:15亩
品种:南美白对虾
养殖户的虾出现甲壳溃疡,灰腮等症状态,进行了弧菌检测,发现弧菌超标
处理方法
①外泼中仁金碘(2亩水体/瓶),内服弧立净(40斤料/瓶)


②消毒6-8小时后,使用补菌专家进行补菌(2亩水体/瓶)

使用3天后,效果展示
本文供稿:孙继才,马玉克
编辑审核:张传宝,臧学运

